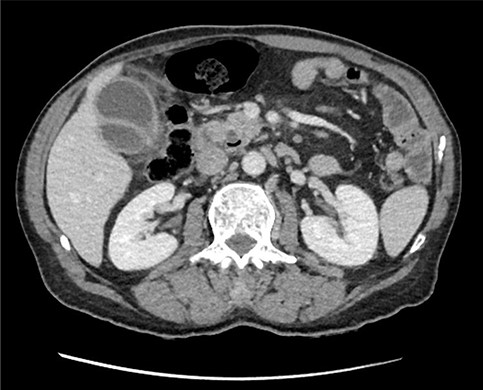
Axial section of preoperative CT abdomen from initial presentation showing thickened gallbladder with pericholecystic fluid; duplicated gallbladder evident, initially thought to be Phrygian cap sign.

-
PDF
- Split View
-
Views
-
Cite
Cite
Wei S Poh, Tulsi Menon, Ruwan Wijesuriya, Philip Misur, Duplicated gallbladder with double cystic duct: hidden in plain sight, Journal of Surgical Case Reports, Volume 2022, Issue 1, January 2022, rjab633, https://doi.org/10.1093/jscr/rjab633
- Share Icon Share
Abstract
Duplicated gallbladder with double cystic duct is a rare anomaly, with 62 cases reported including this case. We present a 76-year-old man who underwent interval laparoscopic cholecystectomy after previous conservative management of acute cholecystitis. Retrograde dissection of gallbladder was performed due to difficult access. Gallbladder was opened at Hartman’s pouch which revealed two bile-flowing structures. Cholangiogram was only successful via one of the ducts with no evidence of leak. Subtotal cholecystectomy was performed after consultation with a Hepatobiliary surgeon. Preoperative computed tomography (CT) and magnetic resonance cholangiopancreatography (MRCP) were reviewed which revealed duplicated gallbladder. CT cholangiogram was performed post-operatively, confirming two separate cystic ducts. Our case emphasizes that anatomical anomalies can still be unappreciated despite having high-resolution CT and MRCP preoperatively, which poses increased risk of biliary tree injury. Routine intraoperative cholangiogram will help avoid bile duct injuries. Literature advises that both gallbladders should be removed to avoid relapse of gallbladder disease.
INTRODUCTION
Laparoscopic cholecystectomy has become the gold standard treatment for gallbladder disease [1]. Performing this procedure can be challenging as there are wide variations of biliary anatomy in about 47% of patients [2]. Having duplicated gallbladder with double cystic ducts is a very rare anomaly with only 62 cases of duplicated gallbladder reported in the literature, including this case [3–9].
We present a case of a 76-year-old man initially treated non-operatively for acute cholecystitis with obstructive pattern liver derangements which resolved spontaneously, an interval laparoscopic cholecystectomy was performed where double cystic ducts were found perioperatively. A subtotal cholecystectomy was completed and computed tomography (CT) cholangiogram was performed Day 1 post-operatively which confirms the diagnosis. Duplicated gallbladders with separate cystic ducts were revealed upon reviewing the patient’s preoperative CT and magnetic resonance cholangiopancreatography (MRCP). The patient recovered well from his surgery with no complications found during his post-operative follow-up. The following case report is presented in line with the SCARE criteria [10].
CASE REPORT
We present a 76-year-old man presented with an acute episode of cholecystitis associated with 5-day history of constant right upper quadrant pain, fever, bloating and 30 kg weight loss over the course of 1 year. Patient was not jaundiced during the examination. His past medical history only included a recent left inguinal hernia mesh repair with no family history of cancers. He denied smoking and alcohol intake. Initial blood investigations showed elevation in white cell count (12.2 × 109/L), c-reactive protein (CRP) (82 mg/L), Bilirubin (46 umol/L), alanine aminotransferase (ALT) (562 U/L), alkaline phosphatase (ALP) (328 U/L) and gamma-glutamyl transferase (GGT) (385 U/L). Lipase level was normal.
A CT abdomen/pelvis was done while patient was commenced on antibiotic therapy. CT abdomen showed signs of cholecystitis with dilated intrahepatic, pancreatic and common bile duct (CBD) with no mass demonstrated. During his admission, his bilirubin peaked at 124 umol/L and CRP raised to 135 mg/L. MRCP was done on Day 2 of admission which showed no evidence of choledocholithiasis or any pancreatic/hepatic lesions and subsequent reduction in intrahepatic and pancreatic duct sizes. Tumour markers were done and it was found that carcinoembryonic antigen (CEA), carbohydrate antigen 19-9 (CA19-9) and alpha-fetoprotein (AFP) were not elevated.
Patient’s cholecystitis was successfully managed with antibiotic therapy while deranged liver enzyme levels improved spontaneously. Patient was discharged on Day 4 and subsequently underwent an interval laparoscopic cholecystectomy 3 months after his initial presentation. Gastroscopy and colonoscopy were also done to exclude gastrointestinal malignancies.
Perioperatively, retrograde dissection of gallbladder was performed due to gallbladder being thick, fibrotic, intrahepatic and access to Calot’s triangle was obscured by dense omental adhesions. Gallbladder was opened at Hartman’s pouch to perform an intraoperative cholangiogram safely; two bile-flowing tube structures were found at base of Hartman’s (Fig. 1). Intraoperative cholangiogram catheter was only able to be performed via one of the two ducts with no evidence of leak (Fig. 2). A Hepatobiliary Surgeon was consulted intraoperatively, the decision was to complete a subtotal cholecystectomy with the stump, containing both lumens, secured with Endoloop ties. 15F Blakes drain was placed at the gallbladder bed.

Intraoperative image showing gallbladder with two duct structures (blue arrows); cystic artery clipped on left (green arrow).

Intraoperative cholangiogram performed via one of two duct structures; double cystic duct not evident.
Subsequent review of preoperative imaging solved the mystery. Duplicated gallbladder with double cystic ducts was clearly evident on CT and magnetic resonance imaging (MRI) which were hidden in plain sight (Figs 4–7). CT cholangiogram (Fig. 3) was performed Day 1 post-operatively showing the double cystic duct with no evidence of bile leak. Rest of patient’s admission was uneventful and he was cleared for discharge on Day 5 post-operatively. Patient remains well and was back to his daily activities during his follow-up review.

CT cholangiogram performed Day 1 post cholecystectomy confirming double cystic ducts.
Axial section of preoperative CT abdomen from initial presentation showing thickened gallbladder with pericholecystic fluid; duplicated gallbladder evident, initially thought to be Phrygian cap sign.


Preoperative T2-weighted MRCP; double cystic ducts seen upon retrospective review of images post cholecystectomy.

3D reconstruction of duplicated gallbladder and biliary tree from MRCP.
CLINICAL DISCUSSION
Anatomical anomalies of the gallbladders and its ducts have been documented from as early as 1926 by Edward Boyden [11]. Autopsy studies by Boyden reported that double gallbladders occur in 0.03% of cases [11]. To date, there have been 62 cases of patients with double gallbladder reported since 1926, including our case [3–9]. Duplicated gallbladders can be classified into three types using Harlaftis Classification: Type I where double gallbladder drains into CBD via one cystic duct, Type II where two separate cystic ducts drain into CBD, and Type III where gallbladder is separated and has duplicated cystic ducts or have triple gallbladder [4]. Given the preoperative MRCP and postoperative CT cholangiogram findings, our case is a Type II accessory gallbladder with ‘H’ duplication.
Identification of double gallbladder and other abnormal biliary anatomy is better picked up with MRCP, compared with ultrasound, as ultrasound is more useful in detecting gallbladder disease but anomalies may not be appreciated [6]. Intraoperative cholangiogram is required to characterize the biliary tree when anatomy is unclear to reduce risk of bile duct injuries, in particular to avoid/identify damage of aberrant right posterior sectoral ducts mimicking double cystic ducts as described by Blumgart and Hann [12, 13]. When double gallbladder is encountered in patients with symptomatic gallbladder, removal of both gallbladders either via laparoscopic or open approach is recommended to avoid complications and relapse of symptoms [4].
CONCLUSIONS
Double gallbladder with double cystic ducts is a very rare biliary anatomy anomaly; failure to recognize it perioperatively exposes the patient to increased risk of bile duct injuries. Our case emphasizes that despite the availability of high-resolution preoperative CT and MRI, anatomical anomalies can still be unappreciated. Routine intraoperative cholangiogram will help characterize variants in biliary anatomy to avoid or identify bile duct injuries. When double gallbladder is encountered, it is advised to remove both to prevent complications and relapse of gallbladder disease. Review of all available preoperative imaging by the operating surgeon will minimize risk of injury in laparoscopic cholecystectomy.
CONFLICT OF INTEREST STATEMENT
None declared.
References
Polychronidis
Munie
Musleh
Kokalj
Vezakis
Boukoucha
Feng
Zhou
Singh
Agha
Boyden
Guajardo-Salinas
Huston